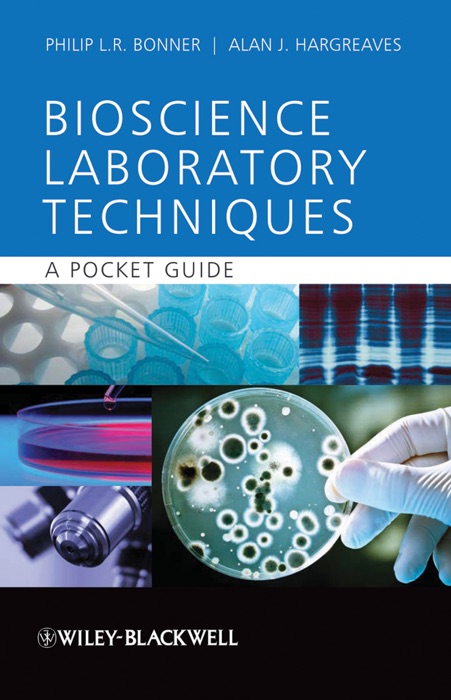

(Download) "Basic Bioscience Laboratory Techniques" by Philip L.R. Bonner & Alan J. Hargreaves * eBook PDF Kindle ePub Free
eBook details
- Title: Basic Bioscience Laboratory Techniques
- Author : Philip L.R. Bonner & Alan J. Hargreaves
- Release Date : January 24, 2011
- Genre: Life Sciences,Books,Science & Nature,
- Pages : * pages
- Size : 3178 KB
Description
This unique, practical, pocket-sized guide and reference provides every first year bioscience student with all they need to know to prepare reagents correctly and perform fundamental laboratory techniques. It also helps them to analyse their data and present their findings, in addition to directing the reader, via a comprehensive list of references, to relevant further reading
All of the core bioscience laboratory techniques are covered including: basic calculations and the preparation of solutions; aseptic techniques; microscopy techniques; cell fractionation ; spectrophotometry; chromatography of small and large molecules: electrophoresis of proteins and nucleic acids and data analysis. In addition the book includes clear, relevant diagrams and worked examples of calculations.
In short, this is a 'must-have' for all first year bioscience students struggling to get to grips with this vitally important element of their course.